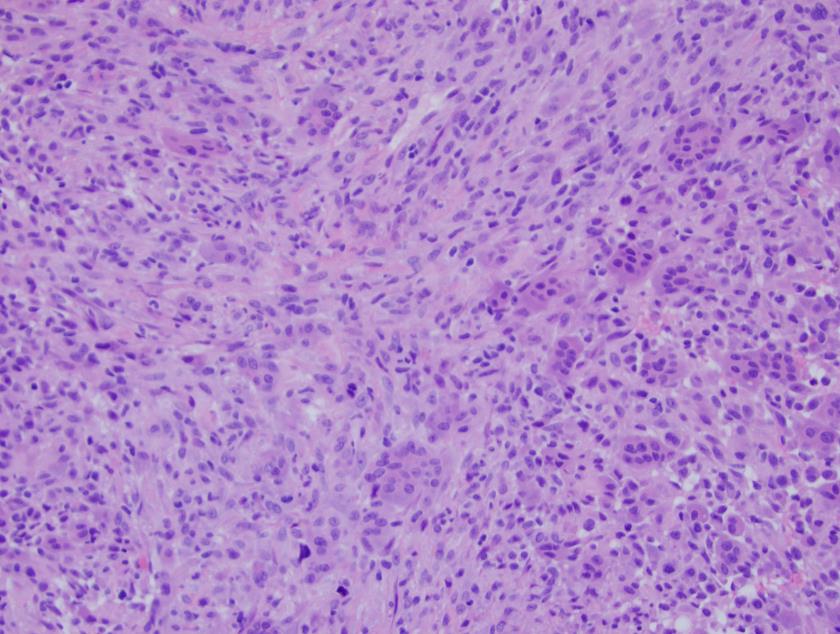

Pathology Case of the Month
Humeral Mass
By: Sachica Cheris, MD, MBA, PGY-4 Associate Chief Resident
Clinical history
43 year old female with 4 weeks of worsening left upper arm and shoulder pain that is throbbing in nature, exacerbated with activity and alleviated by rest.
Past medical history
One year ago, the patient had a left humerus lesion with arm pain and weakness for two weeks.
Imaging
Imaging showed a 5.8 x 5.3 cm lytic expansile lesion in the proximal left humerus. The lesion was also noted on MRI (first photo shown below) and the bone scan. The differential diagnoses included metastasis, giant cell tumor, and possibly myeloma or lymphoma.
The mass was curetted and the histology is shown in the second photo above.
The patient also received treatment with Xgeva and has had no medical issues until this recent shoulder and upper arm pain. A new radiograph was obtained and demonstrated increased bony production superimposed on lytic appearance of the left proximal humeral head and slight increased lateral angulation suggestive of a pathologic fracture (third photo shown above).
An open reduction and internal fixation of left proximal humerus pathologic fracture as well as a curettage of the bone lesion was performed, followed by cryotherapy and cement augmentation. We received 8.5 x 8 x 2 cm of tan-pink to tan-yellow, irregular fragments of soft tissue that were focally calcified.